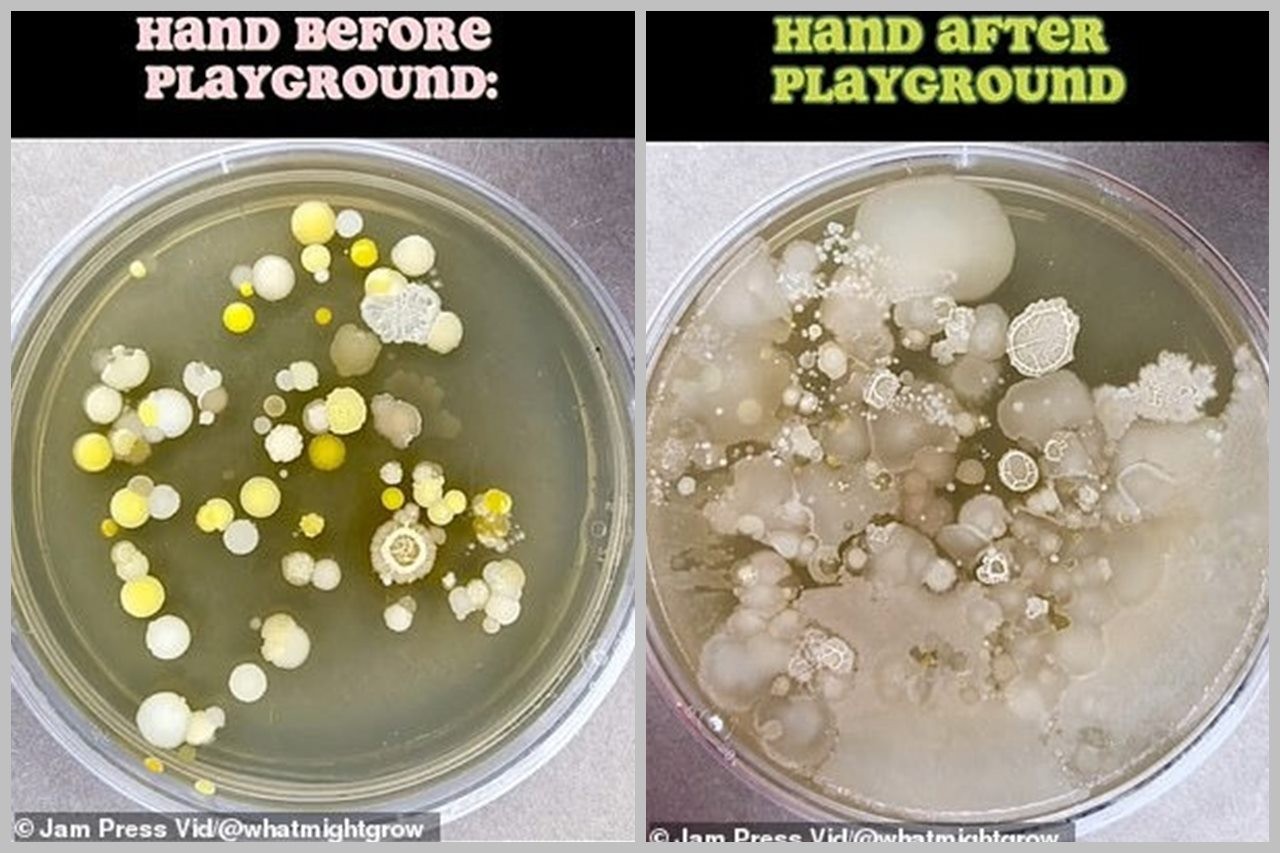
Tim có phát hiện kỳ ​​lạ khi so sánh lượng vi khuẩn trên tay trẻ trước và sau một giờ ở sân chơi công viên.

Theo Dailymail, ngày 7/11, nhà vi trùng học Tim Call, 32 tuổi, đến từ Utah tiết lộ có hàng nghìn vi khuẩn được tìm thấy ẩn nấp trên tay trẻ em chỉ sau một giờ chơi ở công viên. Công viên là địa điểm yêu thích của nhiều trẻ em trên thế giới, đây cũng là sân chơi dành cho trẻ em và phụ huynh vào các dịp cuối tuần. Tuy nhiên, phát hiện mới của nhà vi trùng học Tim Call dấy lên nhiều lo ngại về vấn đề sức khỏe của trẻ em.

Đây không phải lần đầu tiên Tim Call đưa tới những thông tin đáng lo ngại về ván đề sức khỏe đặc biệt là đối với những người sợ vi trùng, vi khuẩn. Trước đó, ông từng tiết lộ những chi tiết gây sốc về máy sấy tay hay bồn rửa bát. Nhà vi trùng học thường xuyên kiểm tra vi khuẩn từ những vật dụng thông thường cho tới những việc làm được cho là cơ bản nhất của con người.
Trong thử nghiệm mới nhất của mình, nhà khoa học 32 tuổi có hơn 270.000 người theo dõi trên mạng xã hội đã chia sẻ một clip về vi khuẩn trú ngụ trong lòng bàn tay trẻ em trước và sau khi tới công viên chơi đùa. Video thu hút hơn 287.700 lượt xem và 20.000 lượt thích.
Tim đã có phát hiện kỳ lạ khi so sánh lượng vi khuẩn trên tay của một đứa trẻ trước và sau một giờ ở sân chơi công viên.

Tim bắt đầu bằng việc kiểm tra bàn tay của trẻ trước khi đến sân chơi, trên đĩa petri. Sau khi đợi 10 phút, anh phát hiện ra có một vài vi khuẩn nhưng số lượng không đáng kể. Sau đó, nhà vi sinh vật học cho đứa trẻ đi chơi nhiều trò chơi ở công viên như trượt cầu trượt, ghế bập bênh,...
Sau một giờ chơi đùa, cậu bé quay trở lại phòng nghiên cứu của Tim đặt tay lên một đĩa petri khác để lấy mẫu sau đó mới đi vào nhà vệ sinh rửa tay bằng xà bông. Nhà vi sinh vật học mang mẫu về nhà để nghiên cứu.
Sau khi nghiên cứu dưới kính hiển vi, Tim kinh ngạc khi phát hiện ra có hàng nghìn vi khuẩn và những mảng nấm lớn trong lòng bàn tay đứa trẻ. "Tôi muốn làm video ở sân chơi công viên để chứng minh rằng vi khuẩn có ở khắp mọi nơi. Tôi cảm thấy đây là là một cách thú vị để thể hiện quan điểm của mình, và tôi đã đúng", Tim nói.

"Mục tiêu của tôi là có thể cho mọi người thấy mức độ tăng trưởng vượt bậc của vi khuẩn ở một địa điểm có lượng người qua lại cao nhất. Bằng cách ghi lại khoảnh khắc này, tôi muốn nhấn mạnh tầm quan trọng của việc rửa tay sau khi đến những nơi như thế này", Tim nói thêm.
Video của Tim Call nhanh chóng được người dùng chia sẻ với tốc độ chóng mặt. Một phụ huynh nhắn nhủ: "Đây là lý do tại sao tôi ngay lập tức vệ sinh tay của bọn trẻ sau khi chơi đùa".
"Sau khi xem xong clip này sự lo lắng của tôi còn tăng cao hơn, bọn trẻ rất thích tới chơi ở công viên", một người phản hồi.
Trong khi đó, một tài khoản khác bình luận: "Đứa con hai tuổi của tôi không thể về nhà mà không liếm ngón tay vào một lúc nào đó, đây là vấn đề rất đáng lo ngại".
Tim đã thực hiện nhiều thí nghiệm trong nhiều năm liên quan đến vi khuẩn vì vi trùng.
"Thứ sạch nhất mà tôi thử nghiệm khiến tôi ngạc nhiên là máy bơm xăng ở trạm xăng", anh nói.
"Tôi nghĩ chúng sẽ chứa đầy vi khuẩn do sử dụng nhiều nhưng thật ngạc nhiên khi thấy chúng phát triển rất ít, chỉ có 5 vi khuẩn nằm trên bề mặt mà thôi", Tim chia sẻ.
Ảnh: Dailymail.


